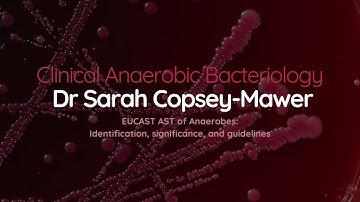
Dr Sarah Copsey-Mawer: EUCAST AST of Anaerobes Identification and significance

⬇ DOWNLOAD NOW
Kalau muncul iklan pop-up, tutup lalu klik tombol kembali
Download lagu ‘It's the pre-analytical part which is most valuable & most prone to errors’ says Prof. Ashok Rattan secara gratis hanya untuk keperluan promosi. Dukung artis favorit kamu dengan membeli musik original di iTunes atau platform resmi lainnya.
 Advances in Immunochemistry & Clinical Impact | Prof. Ashok Rattan | HORIBA Symposium
Advances in Immunochemistry & Clinical Impact | Prof. Ashok Rattan | HORIBA Symposium
 Pre-Analytical Errors in Laboratory Testing: The Impact of Incomplete Request Forms
Pre-Analytical Errors in Laboratory Testing: The Impact of Incomplete Request Forms
 Pre-analytical Errors
Pre-analytical Errors
 Doctor’s Day-July 1st -Prof. Ashok Rattan- Redcliffe Labs
Doctor’s Day-July 1st -Prof. Ashok Rattan- Redcliffe Labs
 JSS Series-57 | Sep'2025 |JMitra Scientific Seminar|Prof.Ashok Rattan|WHO Guidance for Lab Diagnosis
JSS Series-57 | Sep'2025 |JMitra Scientific Seminar|Prof.Ashok Rattan|WHO Guidance for Lab Diagnosis
 Pre-analytical, analytical & post analytical errors in laboratory @mltinformations3289
Pre-analytical, analytical & post analytical errors in laboratory @mltinformations3289
 Innovation in TB Diagnosis | Prof. Ashok Rattan, Chairman - Medical Committee | Redcliffe Labs
Innovation in TB Diagnosis | Prof. Ashok Rattan, Chairman - Medical Committee | Redcliffe Labs
Dr Sarah Copsey-Mawer: EUCAST AST of Anaerobes Identification and significance
Dr Sarah Copsey-Mawer: EUCAST AST of Anaerobes Identification and significance